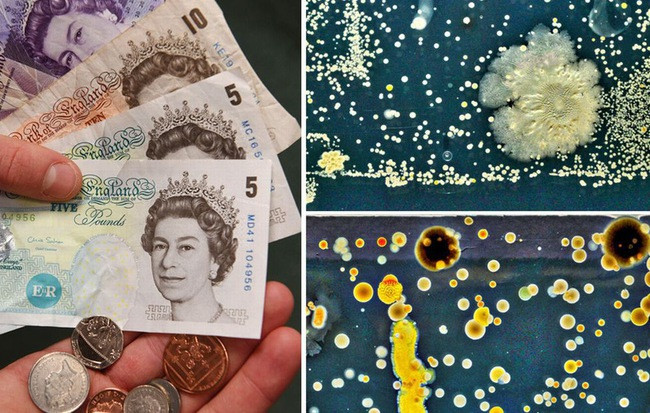
Cực sốc khi biết tiền polymer chúng ta vẫn dùng có thể BẨN đến như thế nào

2 năm gần đây, Singapore có một nhà khoa học kỳ lạ. Ông xuất hiện ở những nơi công cộng, tay lau từng hàng ghế ngồi trong công viên, từng thanh chắn cầu thang tại trạm tàu điện MRT. Ông là tiến sĩ Niranjan Nagarajan - nhà khoa học từ Viện di truyền Singapore, và lý do ông làm vậy là để nghiên cứu về mật độ vi khuẩn nơi công cộng.
Tuy nhiên trong quá trình ấy, ông chợt nhận ra có một khía cạnh rất thú vị về vi khuẩn nhưng chưa từng được thực hiện, hoặc có thì rất hãn hữu và chắc chắn chưa từng xảy ra ở Singapore.
Đó cũng chính là nền tảng để tiến sĩ Nagarajan thực hiện nghiên cứu mới đây, về số lượng vi khuẩn có mặt trên một tờ tiền.
Tiến sĩ Nagarajan cùng cộng sự là tiến sĩ Swaine Chen và Simon Tan có chung quan điểm rằng: nếu lo ngại về mức độ vi khuẩn tại những nơi công cộng, thì tiền cũng nên được xem xét thật cẩn thận.
Trước kia, đã từng có một nghiên cứu tương tự như vậy tại New York, và khoa học đã tìm ra tới 3.000 loại vi khuẩn trên chỉ một tờ 1$. Trong đó có những loại gây dị ứng da, viêm ruột và ngộ độc thực phẩm.
Tuy nhiên, các tờ tiền đô Mỹ được làm từ giấy cotton và lanh - những chất liệu nổi tiếng vì khả năng "nuôi" vi khuẩn. Trong khi đó, tiền đô Singapore được làm từ polymer giống như tiền đồng của Việt Nam. Vật liệu này cho phép tờ tiền ít bị ngấm nước, do đó bền hơn các loại tiền giấy thông thường rất nhiều.
Nhưng về độ vệ sinh thì sao nhỉ? Nghiên cứu của Nagarajan đã cho thấy một kết quả đáng giật mình.
Tiền polymer ở đâu là bẩn nhất?
Bồn cầu hay đôi giày bạn đi dã chiến hàng ngày bẩn thì... khỏi cần bàn rồi. Trong thử nghiệm của Nagarajan, số lượng vi khuẩn trên tiền cực khủng.
Thậm chí, nếu so với điện thoại di động và giẻ rửa bát - 2 vật dụng vốn đã được chứng minh là bẩn nhất, lượng vi khuẩn có thể coi là một 9 - một 10.
Cụ thể, những tờ tiền trong thử nghiệm được thu thập ở nhiều nơi khác nhau: bệnh viện, siêu thị, chợ "xổm", Hawker centre (các trung tâm ẩm thực của Singapore), cây ATM... tổng cộng 100 địa điểm, với mệnh giá từ 2 - 50 đô.
Kết quả, những đồng tiền lấy từ các khu chợ bán thực phẩm tươi sống chứa lượng vi khuẩn nhiều nhất - trung bình 48.000 vi khuẩn/tờ. Con số này nhiều gấp 1.000 lần những tờ tiền mới cứng được lấy trong máy ATM, và 48 lần so với tiền có trong bệnh viện.
Tiền trong các trung tâm thực phẩm Hawker có lượng vi khuẩn là 3.500, trong khi tiền ở bệnh viện là 1.000. Tiền ở các siêu thị thì ít hơn, chỉ khoảng 120 vi khuẩn/tờ.
Ngoài ra, các xét nghiệm cho thấy tiền không chỉ có dấu vết của con người, mà còn có ADN của gia súc, gia cầm và vật nuôi nữa.
Tại sao tiền ở chợ bẩn nhất?
Theo tiến sĩ Chen, lý do tiền trong các khu chợ bẩn đến vậy là vì chúng thường xuyên dính nước.
Tất cả các loại vi khuẩn đều cần nước để phát triển. "Môi trường vi khuẩn có thể phát triển là những nơi tối tăm, ẩm ướt và nhiệt độ ấm." - ông cho biết.
"Bạn cầm 1 tờ tiền ướt và đặt nó vào ví, thân nhiệt của bạn sẽ biến cái ví thành một môi trường cực kỳ lý tưởng cho vi khuẩn phát triển. Nếu tiền khô thì mọi chuyện đã không như vậy."
Cực sốc khi biết tiền polymer chúng ta vẫn dùng có thể BẨN đến như thế nào
Số vi khuẩn này độc hại đến đâu?
Có nhiều loại vi khuẩn! Đến sữa chua, phô-mai chúng ta ăn mỗi ngày cũng là tổ hợp những vi khuẩn bên trong. Vậy vấn đề là số vi khuẩn trên tiền độc hại đến mức nào?
Theo Chen, không phải cứ nhiều vi khuẩn là độc. Nó phụ thuộc vào loại vi khuẩn, và hệ miễn dịch của chúng ta. Ví dụ như E. Coli là một trong những vi khuẩn thấy nhiều nhất trên tiền, nhưng nó cũng là loại khuẩn vốn trú ngụ trong cơ thể chúng ta, nghĩa là tương đối vô hại (dù một số dòng E. Coli có thể gây tiêu chảy).
Trong khi đó, khuẩn staphylococcus (tụ cầu vàng) thì nguy hiểm hơn. Loại khuẩn này có thể gây viêm màng não, khiến người bệnh tử vong với tỉ lệ rất cao.
"Một số chủng khuẩn có thể khiến một người tử vong" - tiến sĩ Tan cho biết. "Nhưng nếu như bạn có một hệ miễn dịch hoạt động tốt, bạn sẽ ổn thôi."
Tuy vậy, vi khuẩn trên tiền giấy là một hiện thực đáng lo ngại. Nếu không cẩn thận, số vi khuẩn ấy có thể tiến vào cơ thể chúng ta qua đường ăn uống, qua vết thương hở, hoặc đơn giản chỉ là bạn mắt một cái. Thế nên, lời khuyên chuẩn nhất cho mỗi chúng ta là nên rửa tay thật cẩn thận sau khi chạm vào tiền.
Tuy nhiên trong quá trình ấy, ông chợt nhận ra có một khía cạnh rất thú vị về vi khuẩn nhưng chưa từng được thực hiện, hoặc có thì rất hãn hữu và chắc chắn chưa từng xảy ra ở Singapore.
Đó cũng chính là nền tảng để tiến sĩ Nagarajan thực hiện nghiên cứu mới đây, về số lượng vi khuẩn có mặt trên một tờ tiền.
Tiến sĩ Nagarajan cùng cộng sự là tiến sĩ Swaine Chen và Simon Tan có chung quan điểm rằng: nếu lo ngại về mức độ vi khuẩn tại những nơi công cộng, thì tiền cũng nên được xem xét thật cẩn thận.
Trước kia, đã từng có một nghiên cứu tương tự như vậy tại New York, và khoa học đã tìm ra tới 3.000 loại vi khuẩn trên chỉ một tờ 1$. Trong đó có những loại gây dị ứng da, viêm ruột và ngộ độc thực phẩm.
Tuy nhiên, các tờ tiền đô Mỹ được làm từ giấy cotton và lanh - những chất liệu nổi tiếng vì khả năng "nuôi" vi khuẩn. Trong khi đó, tiền đô Singapore được làm từ polymer giống như tiền đồng của Việt Nam. Vật liệu này cho phép tờ tiền ít bị ngấm nước, do đó bền hơn các loại tiền giấy thông thường rất nhiều.
Nhưng về độ vệ sinh thì sao nhỉ? Nghiên cứu của Nagarajan đã cho thấy một kết quả đáng giật mình.
Tiền polymer ở đâu là bẩn nhất?
Bồn cầu hay đôi giày bạn đi dã chiến hàng ngày bẩn thì... khỏi cần bàn rồi. Trong thử nghiệm của Nagarajan, số lượng vi khuẩn trên tiền cực khủng.
Thậm chí, nếu so với điện thoại di động và giẻ rửa bát - 2 vật dụng vốn đã được chứng minh là bẩn nhất, lượng vi khuẩn có thể coi là một 9 - một 10.
Cụ thể, những tờ tiền trong thử nghiệm được thu thập ở nhiều nơi khác nhau: bệnh viện, siêu thị, chợ "xổm", Hawker centre (các trung tâm ẩm thực của Singapore), cây ATM... tổng cộng 100 địa điểm, với mệnh giá từ 2 - 50 đô.
Kết quả, những đồng tiền lấy từ các khu chợ bán thực phẩm tươi sống chứa lượng vi khuẩn nhiều nhất - trung bình 48.000 vi khuẩn/tờ. Con số này nhiều gấp 1.000 lần những tờ tiền mới cứng được lấy trong máy ATM, và 48 lần so với tiền có trong bệnh viện.
Tiền trong các trung tâm thực phẩm Hawker có lượng vi khuẩn là 3.500, trong khi tiền ở bệnh viện là 1.000. Tiền ở các siêu thị thì ít hơn, chỉ khoảng 120 vi khuẩn/tờ.
Ngoài ra, các xét nghiệm cho thấy tiền không chỉ có dấu vết của con người, mà còn có ADN của gia súc, gia cầm và vật nuôi nữa.
Tại sao tiền ở chợ bẩn nhất?
Theo tiến sĩ Chen, lý do tiền trong các khu chợ bẩn đến vậy là vì chúng thường xuyên dính nước.
Tất cả các loại vi khuẩn đều cần nước để phát triển. "Môi trường vi khuẩn có thể phát triển là những nơi tối tăm, ẩm ướt và nhiệt độ ấm." - ông cho biết.
"Bạn cầm 1 tờ tiền ướt và đặt nó vào ví, thân nhiệt của bạn sẽ biến cái ví thành một môi trường cực kỳ lý tưởng cho vi khuẩn phát triển. Nếu tiền khô thì mọi chuyện đã không như vậy."
Cực sốc khi biết tiền polymer chúng ta vẫn dùng có thể BẨN đến như thế nào
Số vi khuẩn này độc hại đến đâu?
Có nhiều loại vi khuẩn! Đến sữa chua, phô-mai chúng ta ăn mỗi ngày cũng là tổ hợp những vi khuẩn bên trong. Vậy vấn đề là số vi khuẩn trên tiền độc hại đến mức nào?
Theo Chen, không phải cứ nhiều vi khuẩn là độc. Nó phụ thuộc vào loại vi khuẩn, và hệ miễn dịch của chúng ta. Ví dụ như E. Coli là một trong những vi khuẩn thấy nhiều nhất trên tiền, nhưng nó cũng là loại khuẩn vốn trú ngụ trong cơ thể chúng ta, nghĩa là tương đối vô hại (dù một số dòng E. Coli có thể gây tiêu chảy).
Trong khi đó, khuẩn staphylococcus (tụ cầu vàng) thì nguy hiểm hơn. Loại khuẩn này có thể gây viêm màng não, khiến người bệnh tử vong với tỉ lệ rất cao.
"Một số chủng khuẩn có thể khiến một người tử vong" - tiến sĩ Tan cho biết. "Nhưng nếu như bạn có một hệ miễn dịch hoạt động tốt, bạn sẽ ổn thôi."
Tuy vậy, vi khuẩn trên tiền giấy là một hiện thực đáng lo ngại. Nếu không cẩn thận, số vi khuẩn ấy có thể tiến vào cơ thể chúng ta qua đường ăn uống, qua vết thương hở, hoặc đơn giản chỉ là bạn mắt một cái. Thế nên, lời khuyên chuẩn nhất cho mỗi chúng ta là nên rửa tay thật cẩn thận sau khi chạm vào tiền.